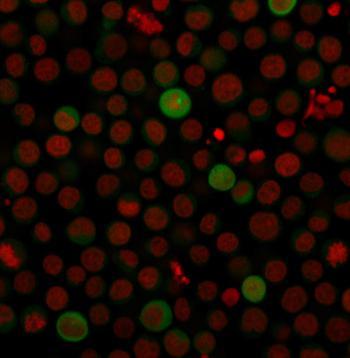

Anti-PD-L1 / PDCD1LG1 / CD274 / B7-H1 (Cancer Immunotherapy Target) Monoclonal Antibody(Clone: PDL1/2743)
Fig. 1: Immunofluorescence Analysis of human Jurkat cells labeling PD-L1 with PD-L1 Mouse Monoclonal Antibody (PDL1/2743) followed by Goat anti-Mouse IgG-CF488 (Green). The nuclear counterstain is Reddot (Red)
Roll over image to zoom in
Shipping Info:
For estimated delivery dates, please contact us at [email protected]
Amount : | 100 µg |
Isotype : | Mouse IgG2b, kappa |
Content : | 200 µg/ml of Ab Purified from Bioreactor Concentrate by Protein A/G. Prepared in 10mM PBS with 0.05% BSA & 0.05% azide. Also available WITHOUT BSA & azide at 1.0mg/ml. |
Storage condition : | Antibody with azide - store at 2 to 8°C. Antibody without azide - store at -20 to -80°C. Antibody is stable for 24 months. Non-hazardous. |
PD-L1 is a checkpoint regulator in immune cells, it is expressed on immune or non-hematopoietic cells. Expression of the protein is seen during pregnancy where it has a role in suppressing the immune system. PD-L1 induces an inhibitory signal in activated T-cells and promotes T-cell apoptosis. It is overexpressed in a number of different cancers where it is believed to play a significant role in the cancer s ability to evade the immune system.
ELISA (For coating, order antibody without BSA);,Flow Cytometry (1-2ug/ml);,Immunofluorescence (1-2ug/ml);,
For Research Use Only. Not for use in diagnostic/therapeutics procedures.
There are currently no product reviews
|